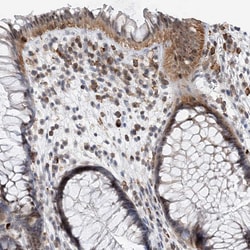
Invitrogen PRMT9 Polyclonal Antibody 100 &mu;L; Unconjugated:Antibodies,

missing translation for 'onlineSavingsMsg'
Learn More
Learn More
Invitrogen™ PRMT9 Polyclonal Antibody


Rabbit Polyclonal Antibody
Brand: Invitrogen™ PA557845
This item is not returnable.
View return policy
Description
Immunogen sequence: HTKSLDIEIP KHIPERVSLV VTETVDAGLF GEGIVESLIH AWEHLLLQPK TKGESANCEK YGKVIPASAV IFGMAVECAE IRRHHRVGIK DIAGIHLPT Highest antigen sequence identity to the following orthologs: Mouse - 92%, Rat - 89%.
Substrate recognition component of a SCF (SKP1-CUL1-F-box protein) E3 ubiquitin-protein ligase complex which mediates the ubiquitination and subsequent proteasomal degradation of target proteins, such as DTL/CDT2, BCL6 and PRDM1/BLIMP1. The SCF(FBXO11) complex mediates ubiquitination and degradation of BCL6, thereby playing a role in the germinal center B-cells terminal differentiation toward memory B-cells and plasma cells. The SCF(FBXO11) complex also mediates ubiquitination and degradation of DTL, an important step for the regulation of TGF-beta signaling, cell migration and the timing of the cell-cycle progression and exit. Binds to and neddylates phosphorylated p53/TP53, inhibiting its transcriptional activity. SCF(FBXO11) does not seem to direct ubiquitination of p53/TP53.
Specifications
| PRMT9 | |
| Polyclonal | |
| Unconjugated | |
| PRMT9 | |
| AI931714; Prmt10; PRMT9; protein arginine methyltransferase 10 (putative); protein arginine methyltransferase 9; Protein arginine N-methyltransferase 10; Protein arginine N-methyltransferase 9; putative protein arginine N-methyltransferase 10; putative protein arginine N-methyltransferase 9; RGD1306157 | |
| Rabbit | |
| Antigen Affinity Chromatography | |
| RUO | |
| 90826 | |
| Store at 4°C short term. For long term storage, store at -20°C, avoiding freeze/thaw cycles. | |
| Liquid |
| Immunohistochemistry (Paraffin) | |
| 0.2 mg/mL | |
| PBS with 40% glycerol and 0.02% sodium azide; pH 7.2 | |
| Q6P2P2 | |
| PRMT9 | |
| Recombinant protein corresponding to Human PRMT9. Recombinant protein control fragment (Product #RP-96723). | |
| 100 μL | |
| Primary | |
| Human | |
| Antibody | |
| IgG |
Product Content Correction
Your input is important to us. Please complete this form to provide feedback related to the content on this product.
Product Title
Spot an opportunity for improvement?Share a Content Correction